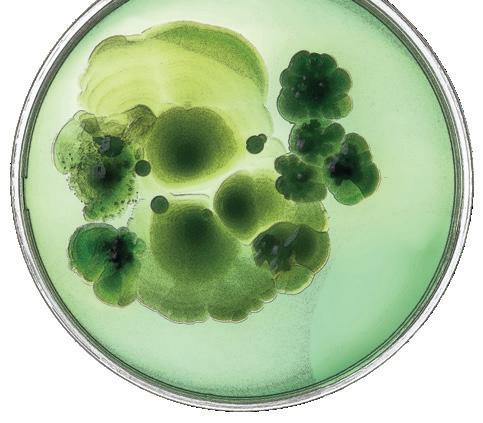

![]()









BY DEAN GLEN SCHUMOCK
I hope that title got your attention! Welcome to the spring 2025 issue of The Pharmacist—where you will find stories involving goose poop, artificial intelligence, and rural pharmacy—to name a few!
What, pray tell, would a story involving goose poop be doing in a prestigious magazine like this? Well, goose poop is where a middle schooler named Camarria Williams may have helped discover a new compound that inhibits the growth of cancer cells. That’s right! Camarria, who was age 11 at the time, participated in a 14-week program led by UIC Retzky College of Pharmacy professor Brian Murphy with the Boys and Girls Club of Chicago. During the program, students from underserved communities experienced hands-on, the process of antibiotic drug discovery. You will read about Camarria, Brian, and others involved in this exciting and novel program within.

Perhaps the experience that Camarria had will lead her to a career in research or healthcare. Maybe she will come to UIC and pursue pharmacy! If she does, she will learn from faculty that are at the cutting edge of innovation in pharmacy education, research, and service. This is illustrated in the story in this issue on generative artificial intelligence (AI) and how it is being used in the classroom at the UIC Retzky College of Pharmacy. When integrated effectively into our curriculum, we believe AI can enhance knowledge delivery, improve student learning outcomes, and better equip graduates for career success.
While the program Dr. Murphy leads, described above, focuses on inner-city youth, the UIC Retzky College of Pharmacy is also working hard to ensure that we meet the needs of rural communities—where healthcare is sometimes hard to find. That brings me to another article in this issue—one that describes the Rural Pharmacy (RPharm) program housed at our Rockford campus and directed by Dr. Heidi Olson. That program got a big boost this year thanks to a
go.uic.edu/PharmFBChicago go.uic.edu/PharmFBRockford
go.uic.edu/PharmTwitter
go.uic.edu/PharmLinkedIn
go.uic.edu/PharmInstagram
go.uic.edu/PharmYouTube
Change jobs? Get a promotion? Publish a paper? Publish a book? Get married? Have a baby? We want to hear about it all! Submit your updates at go.uic.edu/retzky
grant from the McKesson Foundation with the goal to increase the pipeline of pharmacists trained to work in rural areas. The grant provides resources for conducting youth pharmacy camps across the state to spark interest in pharmacy careers. It also supports our rural pharmacy course curriculum; experiential opportunities in rural settings; and engagement with rural pharmacists, including continuing education offerings.
The stories in this issue describe just a few of the great things that are happening at the UIC Retzky College of Pharmacy. As dean, I have the enviable pleasure of witnessing firsthand the many other accomplishments of our faculty, staff, students, and residents and other trainees. I also have the humbling knowledge that their success is fueled by the generous support and engagement of our alumni and partners. Alumni like Mike Moritz, BS Pharm ’72, who with his wife, Ana, created a new endowed scholarship for pharmacy students—the first under our Legacy Scholarship matching program, which you can read about within. Or alumni like Sandra Salverson, PharmD ’96, profiled in this issue, who is senior vice president of pharmacy services at OSF HealthCare. She and OSF Healthcare are fantastic partners for student clinical training.
Together, Sandra, Mike, Heidi, Brian, and the entire UIC Retzky College of Pharmacy family are changing healthcare and changing lives. Our Digital Edition
issuu.com/uicpharmacy

University of Illinois Chicago Retzky College of Pharmacy Office of Continuing Education and Meeting Services (OCEMS) offers continuing education courses for pharmacists, pharmacy technicians, and pharmaceutical representatives. See below for more information.
PHARMACY TECHNICIAN CE PROGRAMS
ACPE-approved pharmacy technician continuing education programs are available. For more information, please visit ce.pharmacy.uic.edu/ce/pharmtechs
PHARMACIST CE PROGRAMS
ACPE-approved pharmacist continuing education programs are available. For more information, please visit ce.pharmacy.uic .edu/ce/pharmacist
PHARMACEUTICAL REPRESENTATIVE PROGRAMS
Pharmaceutical representative continuing education programs are available for the City of Chicago and the State of Oregon. For more information, please visit ce.pharmacy.uic.edu/ce /pharmaceutical-representatives
ILLINOIS TRANSPLANT PHARMACISTS ASSOCIATION (ITPA) SYMPOSIUM
Please save the date for the 8th annual Illinois Transplant Pharmacists Association (ITPA) Symposium to be held at UIC Retzky College of Pharmacy on Saturday, October 4, 2025. More information coming soon!
If you have questions or suggestions for future programs, please contact us at pharmce@uic.edu.

Dr. Maya Campara received the American College of Clinical Pharmacy (ACCP) Editor’s Choice Award for her paper “Consensus Recommendations for the Use of Maintenance Immunosuppression in Solid Organ Transplantation” published in Pharmacotherapy Dr. Maya Campara was also appointed associate editor (clinical pharmacology) for Transplantation, the journal of the Transplantation Society.

THE MCKESSON CORPORATION FOUNDATION
AWARDED $864,000 TO THE RURAL PHARMACY PROGRAM. The program, headed by Dr. Heidi Olson, focuses on rural interventions and training pharmacy professionals to serve rural populations.

Dr. Rob DiDomenico received the American College of Clinical Pharmacy Cardiology Practice and Research Network (PRN) Service Award recognizing his significant lifetime contributions and service to the PRN, healthcare institutions, and professional organizations.

Dr. Jeff Mucksavage received a Presidential Citation for his service to the Neurocritical Care Society (NCS). Dr. Mucksavage was also named to the NCS Credentials Committee. Congratulations!

Dr. Kirsten Ohler received the ACCP Pediatrics PRN Chair Award.

Dr. Jessica Tilton was appointed a fellow of the American College of Clinical Pharmacy (FCCP).

Dr. Taylor Watterson was appointed committee chairelect to American Pharmacists Association’s (APhA) WellBeing Advisory Committee. Dr. Watterson was also honored with the Chicago Association for Women in Science 2024 Motivator Award. “Dr. Watterson has promoted changes in patient care, conducting essential research in practices."
Angeliki Andrianopoulos received a 2024 Travel Award for PhD Students (TAPS) from the Retzky College of Pharmacy.

Dahee Jung was awarded the 2024 Korean Honor Scholarship (KHS).

Kiran Pentela and Elma Abdulbaki are members of the Drug Information Association student board.


Bintou Timbine and Armin Pashaeimofrad were awarded the ICHP Rising Star Award.


The Illinois Council of Health System Pharmacists (ICHP) recognized several members of the UIC Retzky College of Pharmacy community with awards. UIC honorees are:
ICHP Shining Star Awardees
Vince Oluwaleke, Assistant Director of Pharmacy and Clinical Instructor/Clinical Pharmacist in Pharmacy Practice
Armin Pashaeimofrad, PharmD ’24, UIC PGY1 2025
John Shilka, Clinical Assistant Professor of Pharmacy Practice
Joseph Simon, Clinical Assistant Professor of Pharmacy Practice
Bintou Timbine, Student Pharmacist, Class of 2025
Kay Yamamoto, Clinical Assistant Professor of Pharmacy Practice
Other UIC Awardees
Rita Edwards, Pharmacy Technician at UI Health, received the Technician Award
Carol Heunisch, BS Pharm ’84, PharmD ’98, received the Immediate Past President Award

Brittany Karas, PharmD ’17, received the New Practitioner Leadership Award
Hina Patel, PharmD ’98, received the Amy Lodolce Mentorship Award
The college celebrated its annual Research Day on November 1, 2024. Hosted by the college’s Office of Research and Graduate Education, this event showcases the research of our students and postdoctoral trainees with nearly 100 posters presented this year. We welcomed keynote speaker James Moon, J. G. Searle Professor of Pharmaceutical Sciences at the University of Michigan. The day concluded with award ceremonies and reception. Congrats to all who were honored at the event! See the full list of honorees at researchday.pharmacy.uic.edu.

INNOVATE@UIC Innovation Award
(presented by the UIC Office of Technology Management)
Edidiong Udofa
Kasra Alizadeh
UI Cancer Center Cancer Science Prize
(presented by the UICancer Center)
Dahee Jung and Xiaoying Cai
Monica Haughan
ISPOR UIC Student Chapter Award
Michael Kim
ISPE UIC Student Chapter Award
Jyoti Sarker
AAPS UIC Student Chapter Choice Award
Bo Zhou
UIC Retzky College of Pharmacy Award for Excellence in Research in Biology: Molecular and Cell Biology; Mechanism of Action
Dmitrii Travin
Meghna Gill
Sobita Pathak
UIC Retzky College of Pharmacy Award for Excellence in Research in Chemistry: Discovery, Modeling, Design, and Evaluation of Novel Drugs; Detection and Delivery Systems
Mario Alvarez
Ana Lopez-Hernandez
Yi-Chien Wu
Jingtian Zheng
UIC Retzky College of Pharmacy Award for Excellence in Research in Clinical, Social, and Applied Sciences
Bertha De Los Santos
Sodam Kim
Scholarship Awards
Al R. Langerman Memorial Scholarship
Sonia Alavi
Angeliki Andrianopoulou
Charles L. Bell Award
Lisa Rusali
Edward Benes Scholarship
Mario Augustinovic
Tatum Johnson
Vitor Lourenzon
Jane Miglo
Ebere Okpara
Sobita Pathak
Jyoti Sarker
Kanya Shah
Nivida Shete
Fleming Endowed Scholarship
Adjo “Elodie” Kadjo
Jin Yi Tan
Jesse E. Stewart Memorial Fellowship
Mrinmayee Joshi
Oscar Robert Oldberg Prize in Pharmaceutical Chemistry
Chih-Jia “Bess” Chao
Ruoci Hu
Professor Ludwig Bauer Scholarship
Destiny Durante
Ralph Henniger Pharmacy Award
Yi Chien Wu
Van Doren Scholarship
John Sloan
Dean’s Fund for Excellence Scholarship
Lisa Rusali
Kent Hanson

Alumnus Steve Swanson, PhD ’90, was awarded UIC Retzky Pharmacy's Research Impact Award. The award honors alumni who distinguished themselves in research and embody the college’s vision to be the global leader in innovative pharmacy research.
We are celebrating the annual Images of Research photo contest winners. The contest challenges researchers to capture iconic images of their work.
JINGTIAN ZHENG
Lee Lab
The Broken Heart Brain

ANGELIKI ANDRIANOPOULOU
Gemeinhart Lab
UIC Shaped for Drug Delivery

See all the 2024 Images of Research submissions here:
ELIE ABI KHALIL Lee Lab
Structures and Patterns of Life and Death








The Class of 2028 White Coat Ceremony marked a significant milestone for our P1 students who were officially welcomed into the field of pharmacy and presented with their white coats, symbolizing their commitment to patient care, ethics, and professional responsibility. Over 600 family and friends gathered in person on both the Rockford and Chicago campuses, and over 1,500 people watched the YouTube livestream to celebrate this important step in students’ careers.
Some quick facts about the Class of 2028:
140 admitted students
3.47 average GPA
63% in-state (Illinois) students
66% hold a bachelor’s degree
22% are underrepresented minorities
72% female, 28% male
Average age of 23 years
Special thanks to Albertsons for serving as this year’s White Coat sponsor.

Brian Murphy leads a team inspiring youth to engage with science and research.
hen Camarria Williams was encouraged to collect field samples in Chicago’s Garfield Park as part of the Chicago Antibiotic Discovery Lab program, she directed a sly smirk in the direction of Dr. Brian Murphy.
“Anything?” the Chicago sixth grader confirmed with Murphy, a professor of pharmaceutical sciences at the UIC Retzky College of Pharmacy who launched the youth science program in 2022 in partnership with the Boys & Girls Clubs of Chicago (BGCC).
Williams soon focused her attention on the lagoon sitting at the park’s center. She surveyed the scene and turned over a few rocks before spotting her target: goose poop.
“I just figured it’d have a lot of bacteria in it because geese eat a lot,” Williams says.
Little did Williams know the sample she collected that rather routine day held a secret: a compound showing activity against a cancer cell line. After
additional investigation by Murphy’s lab team, Williams was listed as a coauthor on a paper published last October in ACS Omega tracking the discovery.
It’s a high-profile result for Murphy’s upstart outreach program, which he designed to engage Chicago youth in biomedical research and propel interest in STEM careers.
“Though the university and the community coexist in the same neighborhood, we can often seem like we’re worlds apart,” says Murphy, who has been involved in youth science outreach throughout much of his 16-year tenure at UIC. “The Antibiotic Discovery Lab program

is about building bridges between UIC and the community it serves and creating shared, impactful experiences around science that motivate and inspire.”
Eager to involve youth in his research around antibiotic discovery in nature, Murphy created the Chicago Antibiotic Discovery Lab after securing a highthroughput robotic colony picker for his lab. Housed in a biosafety cabinet, the robotic machine removed concerns about youth handling bacteria-filled samples and enabled young scientists to get involved in an antibiotic discovery pipeline with support from Murphy and his team.

When Murphy floated the potential program idea to BGCC leadership, they jumped at the opportunity to pilot the initiative at the James R. Jordan Club, which sits 1.2 miles from the Retzky College of Pharmacy’s Wood Street home.
“This was a unique opportunity to get our youth directly involved in research and thinking about science in new ways, so we were all in,” BGCC technology program manager Jonathon Rodriguez says.
The three-month program invites BGCC members into high-level antibiotic research beginning with sample collection in local environments. Thereafter, members grow bacteria from their samples before utilizing the Murphy Lab’s robot to screen the bacteria against


Kids enjoy the everyday connection to science and see it as something attainable
different pathogens. Learning how to read and interpret different bioinformatics data, members then decide which isolates they will hand off to Murphy’s team for further investigation.
Jin Yi “Jeanie” Tan, a fourth-year pharmaceutical sciences graduate student who has helped Murphy run the program since its 2022 debut, has seen members’ confidence rise week after week alongside their willingness to ask questions and chase curiosity.
“We hope that kids see how fun and impactful hands-on science and research can be,” says Tan, who oversees the graduate students and postdocs who serve as the program’s volunteer mentors.
Williams, for instance, relished the program’s experiential nature and the invitation to apply science right in her neighborhood. She also appreciated the opportunity to visit UIC’s labs and receive guidance and encouragement from experienced researchers.
“It was cool to see how it all works,” Williams says.
After the Jordan Club hosted the Antibiotic Discovery Lab’s first two cohorts, the program shifted to the Bartlett J. McCartin Club in Bridgeport last fall. Moving forward, Murphy hopes to bring the program to additional BGCC sites across the Chicago area. His team also partnered with BGCC on a federal grant seeking to expand the program to high schoolers and create paid summer research internships for teens.
“Ultimately, we want to engage as many young people as we can in mentored neighborhood-centred research, so we’re creating interest in science and strengthening the STEM talent pipeline,” Murphy says.
Through the program, Rodriguez has seen participants once intimidated or disinterested in science grow willing and eager to interact with research.
“Kids enjoy the everyday connection to science and see it as something attainable,” he says. “Suddenly, science as a career is something they see as a possibility.”
Williams, who initially joined the program alongside her sister at the suggestion of Jordan Club director Will Edmondson, might be the ideal example of the program’s talent development ambitions. While the preteen enjoyed science before joining the Chicago Antibiotic Discovery Lab, the program intensified her interest in science and ignited visions of pursuing a career in medicine or research.
“The program just made me happy,” she says. “It makes me want to discover more things out there.”

GET FIRED UP ABOUT ALL THE AMAZING INITIATIVES HAPPENING AT THE UIC RETZKY COLLEGE OF PHARMACY.

FOLLOW US ON SOCIAL MEDIA
Be the first to know about all of the college’s events, news, and opportunities to get involved.
Continue receiving our alumni magazine, The Pharmacist
Update your contact information at go.uic.edu/AlumniUpdate.
Whether you’re in Chicago, Rockford, across the country, or around the world, WITNESS WHERE THE SPARK WAS FIRST IGNITED—YOUR ALMA MATER, #UICPHARM.

go.uic.edu/PharmFBChicago go.uic.edu/PharmFBRockford go.uic.edu/PharmTwitter go.uic.edu/PharmInstagram go.uic.edu/PharmLinkedIn

BY MICHAEL DHAR
Generative artificial intelligence (AI)— programs like ChatGPT that can create new content—has swept into industries globally in recent years. Several UIC faculty and students are working to help the UIC Pharmacy community take on the new technology’s promise and risk.
In the spring of 2024, Dr. Faria Munir and Dr. Heather Ipema, clinical assistant professors, led a project in which two students served as AI educators for faculty. The 15-session series aimed to provide students pedagogical and research experience, while also exploring technology training that wouldn’t further tax faculty. As a digital-native, younger population, UIC’s pharmacy students proved ideal candidates for the task.
“We wanted to inform our . . . drug information faculty more about artificial intelligence since it is becoming such a hot topic, not only in education but healthcare in general,” said Munir.
The approach was “an incredible opportunity not only to be involved with the faculty, but also to learn more about AI ourselves,” said Elma Abdulbaki, PharmD ’25, who conducted the sessions with Zeba Saiyad, PharmD ’26.
Topics ranged from prompt engineering to AI tools and regulations. Each session included discussion so attendees could ask questions and explore how AI might affect pharmacy, Sayiad said.
In before-and-after surveys, the program’s research component, professors seemed receptive to the ideas. Among 12 faculty who attended any session, most completed surveys, showing increased knowledge and decreased anxiety about AI. For faculty who’d never used AI, “not only did they realize how much easier it is to use [than they’d thought] but the perceived risk they realized was not as high or . . . was more fueled by misinformation and general fear,” Abdulbaki said.
Even educators beyond UIC have been impressed. Saiyad and Abdulbaki shared poster presentations of their results at the 2024 Retzky UIC College of Pharmacy Research Day and American Society of Health-System Pharmacists Midyear Conference. Afterward, a professor from another school shared that “she found it incredibly encouraging to have students be the ones to teach and report back to the faculty,” Abdulbaki said.
Saiyad and Abdulbaki also coauthored—with Munir and Dr. Jennifer Phillips, clinical professor and Drug Information Group director—an article in the Illinois Council of Health-System Pharmacists “KeePosted” newsletter surveying AI policies and statements by healthcare organizations. “The membership was really trying to figure out what to do with AI and how to feel about AI,” said Phillips, who edits that newsletter, and the November 2024 article aimed to provide “a landscape survey” of AI statements. The students also have a manuscript in the works.
Munir, Phillips, Ipema, and Dr. Kathy Sarna, clinical assistant professor, also secured a grant to study ChatGPT as a writing-evaluation tool. They’ll compare the technology’s performance to humans in grading longer pharmacy papers. “We have historical results of when our faculty have graded these papers,” Phillips said. “We'd like to see how ChatGPT” does.
The project will additionally investigate ChatGPT’s potential for helping pharmacy students improve their writing skills.
Also in spring 2024, Munir and Phillips added a generative AI unit into two core drug information courses. That included a live demonstration asking AI about an FDA safety alert, information that was not yet in ChatGPT but was available in more traditional resources. “We used that to plant the seed that this is not something that you should be utilizing to answer clinical questions,” Phillips said, “and that there are more reputable references.”
Integrating AI into the classroom will only grow in significance, said Saiyad, who took one of the classes. “It's really important that faculty . . . utilize ChatGPT in our learning since it is something we have to deal with now and it's going to be present in our future learnings.”
Many at UIC Pharmacy have already taken advantage of AI’s potential, said Mary Sullivan Kopale, who presented on generative AI at a pharmacy faculty retreat. “I think a lot of faculty are using it [in ways] that we're not even all aware of yet,” said Kopale, director of instructional design and learning innovation. “We're just at the beginning. . . . I think it will be a great tool going forward.”
Kopale’s presentation covered several ways AI could save time in administrative and teaching tasks, such as devising patient cases for recitations. “AI is really good at that. You put in an example of the type of case you're looking for and ask it to change the parameters,” she said. “And something that used to take faculty many hours . . . AI does it in a minute.”
With all AI uses, of course, faculty need to check for accuracy, Kopale warned. Other use cases she shared included quiz writing; creating documents, such as agendas and reference letters; and “ask[ing] it to review your lecture and see if you've missed anything that would be usually taught. . . . You could ask it to reorganize it for you, make it more concise.”
For Dr. Kathryn Sawyer, clinical assistant professor, AI helps greatly by improving communication, such as finetuning instructions. “I just ask it to improve or clarify, or you can ask it to make it more engaging or humorous,” she said. “It doesn't really change what I'm saying, but it definitely makes it clearer.”
Both Dr. Les Hanakahi, associate professor, and Dr. Adam Bursua, clinical assistant professor, use ChatGPT for crafting assessment questions, a first step into AI for many academic users, Bursua said. Most commonly, he said, “I give it questions that I've written . . . throughout the semester” and ask for similar questions for the final. “It does a really good job with that.”
In one unique usage, Sawyer has trained a ChatGPT to play a patient. This helped standardize model patients in her courses, versus the usual method of employing fourth-year students, whose responses may vary. One issue: although the specific ChatGPT instance gets trained only on information Sawyer provides, it can still give away too much at once. “I'm still trying to fine-tune it to only say, ‘I take lisinopril,’ but it ends up saying, ‘I take lisinopril 10 mg by mouth every single day for blood pressure,’” she said. “It's hard to get it to not do that.”
ChatGPT can also save faculty tremendous time in sifting through information from resumes for recommendation letters, Hanakahi said. “Our CVs get into the hundreds of pages, and I can say, ‘ChatGPT, show me just the slice of this enormous document that pertains to this type of service event’ . . . and it'll condense it down into the three or four pages that are relevant.”
Pharmacy users need to be keenly aware of the technology’s potential drawbacks, however. Those include hallucination, in which AI programs invent information that appears factual. “I saw a really scary one the other day, where it just gave the wrong information about a drug,” Bursua said. Only after a few
For faculty . . . the perceived risk they realized was not as high or . . . ChatGPT can We have to remember that
AI should not be used to make clinical
was more fueled by misinformation and general fear. also save faculty tremendous time in sifting through information.
generative AI is based on the internet, and the internet has its own bias. confidently. such as fine-tuning instructions.


corrections from Bursua, who’d queried about drug mechanisms, did the program get the answer right.
AI programs will also contradict themselves, even within the same answer, Hanakahi said. Overall, they can give you the wrong information very confidently, making it easy to be led astray, Bursua said. “It feels like you're talking to somebody who knows their stuff,” he said. “There are no tells.”
All that underscores the need to verify the information— and ensure that the user has the proper knowledge base. “If you utilize it, [and] the information is wrong, you can cause harm,” Phillips said. “So it's very important to validate the information in there. That is, I think, the number one thing.”
UIC faculty also cautioned that AI should not be used to make clinical decisions. Only a person with the appropriate clinical knowledge should do that. “It should not be used for clinical decision-making because the information is not referenced,” Phillips said. “I tell the students to think of this as a new person who you just met, and so when they say things . . . you can't always take it at face value.”
For privacy and liability reasons, researchers also warned that patient and student information should not be uploaded into AI programs.


Bias in AI can become apparent in interesting ways. At the faculty retreat, Kopale asked ChatGPT to present a picture of a dean of a Midwestern college of pharmacy. “It looked very similar to our dean … a middle-aged, white man with facial hair,” she said. Meanwhile, several other nearby Midwestern pharmacy colleges, such as Roosevelt University, have female deans. “We have to remember that generative AI is based on the internet, and the internet has its own bias.”
Overall, pharmacy users should be wary of letting generative AI wholly compose content for them, as opposed to editing drafts about topics they understand well, Sawyer said. “You should not be using ChatGPT to write things [for you]. If you do, you're not an expert,” Sawyer said. “You will have no idea if it’s wrong, if it’s right, but it’s going to sound super convincing.”
As the college embraces the future of AI in education, it is clear that the potential benefits are vast. “When integrated effectively into our curriculum, we believe AI can enhance knowledge delivery, improve student learning outcomes, and better equip graduates for career success,” says Dean Glen Schumock. With a balanced approach of embracing AI’s advantages while staying vigilant about its risks, the UIC Pharmacy community is well on its way to harnessing this transformative technology to better prepare the next generation of pharmacists.
decisions . . . you can't always take it at face value.

312 total donors
$39,841,484 total giving 57% donor retention rate 17% increase and the highest it’s been in 5 years
In 2024, a $36 MILLION GIFT from the estate of two longtime supporters gave the UIC College of Pharmacy a massive push—and a new name, the HERBERT M. AND CAROL H. RETZKY COLLEGE OF PHARMACY .
After donating more than $8 million to the college over the previous two decades—an already impressive sum that made the Retzkys the college’s largest individual philanthropic donor—an endowment gift of an additional $36 million from the couple’s estate cemented the Retzkys’ legacy for advancing pharmacy education at UIC and driving innovative careers in the field. Specifically, the couple’s latest gift will power perpetual programs for merit-based scholarships and career-development initiatives at the college.
“The university’s academic health enterprise is extraordinarily grateful for the Retzkys’ significant philanthropy, which will continue to expand our scholarship and training opportunities for the pharmacy profession,” said vice chancellor for health affairs Dr. Robert Barish. “This investment will benefit future generations of learners and reflect the common legacy of UIC and the Retzkys to serve the needs of our local community and the state.”












11 new endowments established funds were $25K or more
231 students were awarded scholarships during FY24 for a total of $465,639 in scholarship aid

program continues filling a state and national void for pharmacists in rural communities.

BY DANIEL P. SMITH
Dr. Elise Wildman’s story begins in Arthur, Illinois, a town of about 2,200 best known for hosting the state’s oldest and largest Amish community—an undeniable nod to its bucolic setting.
There, Wildman remembers visiting Dicks Pharmacy on Vine Street, which featured both an old-time soda fountain and a pharmacist dispensing medications and healthcare guidance. The liveliness of Dicks inspired a young Wildman’s professional ambitions.
“Way back in second grade, I knew I wanted to be a pharmacist,” she says.
To turn that dream into reality, Wildman enrolled in the UIC Retzky College of Pharmacy in 2011, specifically attracted to the Rural Pharmacy Education (RPHARM) program housed at UIC’s Rockford campus. Today, she serves as the inpatient pharmacist at Kirby Medical Center in Monticello, Illinois, a critical access hospital located about 25 miles north of her childhood home in Lovington, one of Arthur’s neighboring towns.
“I love working in a rural community and helping my friends, family, and neighbors,” Wildman says. “Here, I have more face-to-face interaction and an opportunity to work with people on a more personal level that’s really fulfilling.”
Since graduating its first class in 2014, RPHARM— one of only 20 rural pharmacy programs in the United States.—has propelled dozens of pharmacists like Wildman into rural practice and care for underserved populations.
In Illinois, where 65 of the state’s 102 counties are considered rural, pharmacists remain in short supply. Only one in 10 licensed Illinois pharmacists practice in a rural location, according to industry figures, and the dearth of pharmacists in rural communities has been linked to increased rates of hospital readmission and rising health disparities between rural residents and their urban counterparts.

The college committed itself to putting pharmacists in areas with limited healthcare resources and tackling an important patient care void.
The college committed itself to putting pharmacists in areas with limited healthcare resources and tackling an important

“In many rural communities, pharmacists end up being a first touchpoint, if not a lifeline, because they are the most readily accessible healthcare professional,” says Dr. Kevin Rynn, regional dean for UIC’s Rockford campus. “People come to lean on pharmacists to help them navigate the healthcare arena and receive appropriate care.”
Enter RPHARM, a thoughtfully crafted PharmD concentration preparing students to practice patient-centered, interprofessional pharmacy in rural communities.
UIC launched RPHARM in 2010, the same year the College of Pharmacy established its outpost at the UIC Health Sciences Campus in Rockford. Modeled after the UIC College of Medicine’s longstanding Rural Medicine (RMED) program in Rockford, RPHARM was established to ensure UIC addressed pressing healthcare needs across the state and, in particular, the medically underserved rural areas comprising much of Illinois’s geographic footprint.
“With the RPHARM program, the college committed itself to putting pharmacists in areas with limited healthcare resources and tackling an important patient care void,” says Dr. Allison Schriever, RPHARM’s inaugural director and the current director of pharmacy experiential education on the Rockford campus.
RPHARM imbeds rural-focused course work within UIC’s traditional PharmD curriculum. Over four years, students complete six interprofessional elective courses, three rural healthcare professional shadowing experiences, a community-based research project, and three advanced pharmacy practice experiences in a rural Illinois community. They do much of this alongside students from RMED as well as the UIC College of Nursing’s Rural Nursing (RNURSING) program, an intentional effort to prime students for the interprofessional collaboration rural settings often demand.
“You definitely come to understand the importance of partnerships when working in rural communities because care isn’t so readily available oftentimes,” fourth-year RPHARM student Lauren Johnson says.
Over the last 14 years, RPHARM has successfully prepared a new generation of pharmacists—including some who had never considered rural practice previously—to provide quality services and programs for rural populations.
In fact, 40 percent of RPHARM alumni are working in rural environments across 14 states. In Illinois, where the bulk of RPHARM alumni live and work, graduates are serving residents in 19 counties, from Piatt County (population 16,714) in central Illinois to Jo Daviess County (population 21,756) in the state’s northwest corner. The
vast majority work in either a community (44 percent) or hospital setting (37 percent), while 11 percent practice in a federal government organization and 6 percent work in a long-term care pharmacy.
“We’re growing our own rural workforce. Students are coming to us for specialized training and returning to help the communities they know and love,” current RPHARM director Dr. Heidi Olson says, adding that more than half of RPHARM alumni practice in communities within 50 miles of their hometowns.
Olson labels RPHARM graduates “a community of doers.” They deliver medications to homes and fill knowledge gaps to ensure medication adherence. They develop outreach programming for schools, community centers, and senior facilities. They partner with the local physical therapist to launch walking groups and collaborate with the neighboring nutritionist to lead healthy eating seminars. They serve on community boards and become preceptors and mentors for others interested in rural pharmacy.
“Our graduates are embedded in their communities and meeting needs far beyond the traditional pharmacist’s role,” Olson says. “They are giving back to their communities by employing things they learned in the program, adapted from others, or developed themselves to cultivate healthier lives and make a difference.”
After working in Centralia, Illinois, for eight years, Wildman joined the Kirby Medical Center team in November 2023 as the hospital’s first-ever full-time inpatient pharmacist. She verifies orders, loads medications, and updates the IV room. Her presence fuels faster, more seamless care for patients, including appropriate medication counseling at discharge.
“I’ve had several patients comment that they’ve never had a pharmacist talk to them in a hospital,” says Wildman, who also oversees medication dispensing machines at two remote clinics.
Johnson, who is slated to graduate in the spring, looks to soon join the ranks of pharmacists practicing in rural communities, where she hopes to promote optimal drug therapy and lead community-based efforts like vaccination clinics or educational outreach at schools.
“I see so much I could do that residents need and will appreciate,” Johnson says.
Clinical Pharmacist at Good Samaritan Hospital (Mt. Vernon, Illinois) and St. Mary's Hospital (Centralia, Illinois)
At two downstate hospitals, Loepker covers ICU, internal medicine, surgical, ambulatory care, and discharges—a multifaceted role demanding broad interdisciplinary collaboration to ensure safe transition of care. Her work also includes outpatient IV antibiotic monitoring, price checks, infectious disease management, and “curbside consults” to staff at the PCP/wound specialty clinic on outpatient cases and antibiotic recommendations.

“The daily impact we make as a profession here is most special to me,” says Loepker, who also helped develop a postgraduate residency for individuals interested in becoming a clinical generalist in a community hospital setting.
DR. ANDREW GIBBS ’15
Pharmacist In Charge at Hartig Drug (Stockton, Illinois)
At Hartig, Gibbs delivers traditional pharmacy services, such as providing medication guidance and administering vaccines, but has extended his services far beyond the norm. He’s championed pharmacy’s professional opportunities by speaking at area junior highs and allowing high school students to shadow him. He also partnered with a local nurse practitioner to launch Stockton Healthy and Active, a monthly program highlighting health and wellness topics ranging from sleep hygiene to basic first aid.

“What I enjoy most about working in a rural setting is the sense of community and the difference I feel like I can make in it,” Gibbs says.
DR. ERICA WYCKSTANDT ’19
Assistant Director of Pharmacy at CGH Medical Center (Sterling, Illinois)
Working in both community and hospital pharmacy over the last five years, Wyckstandt has filled many of pharmacy’s typical roles while tackling a few nontraditional tasks as well, like traveling to workplaces and care facilities to vaccinate essential workers and at-risk populations during the COVID-19 pandemic. At CGH, she is active in Jr Healthcare University, a program allowing junior high students to experience daily life in different healthcare professions, including pharmacy. Wyckstandt introduces students to IV admixtures, reading and filling prescriptions, and nonsterile compounding.

“I enjoy being able to build a personal connection with people in my local community while helping educate and address their healthcare needs,” Wyckstandt says.

Our graduates are embedded in their communities and meeting needs far beyond the traditional pharmacist’s role.


Student pharmacist
Jacob Brown was awarded a $1,000 scholarship from the Illinois Rural Health Association.
Inspired by the professional impact of its alumni and the spirit of its current students, RPHARM leaders are working to expand the program’s reach and further address Illinois’s rural pharmacist shortage. The program recently landed a three-year, $860,000 grant from the McKesson Foundation to increase the pipeline of pharmacists trained to meet the healthcare needs of rural communities across the United States. The investment is driving novel programming efforts, such as youth pharmacy camps across the state as well as new opportunities open to all UIC PharmD students, including a rural pharmacy elective and the expansion of experiential learning opportunities in rural environments.
“If you don’t ever hear about pharmacy as an attainable career option, it’s hard to imagine it as part of your future,” Olson reminds.
Another piece of the grant includes creating continuing education programs for current pharmacists. The education will center around serving the needs of rural pharmacists, such as handling medication shortages, optimizing patient health outcomes, and expanding pharmacists’ roles.
Beyond the McKesson Foundation grant, the Retkzy College of Pharmacy is a founding member of the upstart
Rural Pharmacy Consortium. A grassroots effort to collaborate with other institutions teaching rural pharmacy, the consortium prioritizes the sharing of valuable educational content, real-life rural practice perspectives, and programmatic successes and challenges to inform rural pharmacy education across the country.
“We’re committed to spotlighting the healthcare needs of rural communities and how important pharmacy is in these environments,” Olson says. “The more people become aware of this and the more we can shine a light on the impact our students and alumni are having in rural communities, the better we will be positioned to elevate the rural pharmacy workforce and serve the needs of individuals in rural communities.”



Thanks to all who joined our Alumni and Friends Reception and 55th Residency Celebration Reception at American Society of Health-System Pharmacists in New Orleans on December 8, 2024. Over 200 alumni and friends came to celebrate the college’s recent milestones—our college’s 165th anniversary and our residency programs’ 55th anniversary.







Thanks to all who attended the Retzky College of Pharmacy Alumni Reunion on October 19, 2024. We celebrated the following milestone reunion classes: 1974 and before, 1979, 1984, 1989, 1994, 1999, 2004, 2009, 2014, and 2019. We had the most members represented from the 50th reunion class, but we also had a good showing from the 1964 class who were celebrating their 60th class reunion. There were over 90 alumni and guests in attendance. It was a wonderful evening filled with great memories about times past and celebrating our five award recipients:
RISING STAR AWARD 2024
Christopher D. Saffore, PharmD ’16, PhD ’19
JESSE STEWART SERVICE AWARD
Mary L. Moody, BS ’97
LEGACY ACHIEVEMENT AWARD
Ted R. Gladson, BS ’59
LEGACY ACHIEVEMENT AWARD
Jerry L. Bauman, BS ’76
ALUMNI OF THE YEAR AWARD
Pornanong Aramwit , PharmD ’95
We look forward to what the future has in store for the college in the next 165 years. Save the date for the next Alumni Reunion on October 4, 2025.








BY JENNIFER FLYNN

Mike Moritz struggled as a chemical engineering major at the University of Illinois Urbana-Champaign in the late 1960s. “The math was eating me alive, but I loved chemistry!” he recalls. A family friend suggested Moritz move back to his hometown of Chicago to study pharmacy at UIC.
That advice changed the course of Moritz’s life. He transferred to the UIC College of Pharmacy—now the UIC Retzky College of Pharmacy—and discovered his true calling.
“It was the perfect profession for me,” he says. “It satisfied my scientific interests. I especially loved the
art of compounding medications. More surprisingly, pharmacy helped me discover a side of myself I never knew existed. I had always considered myself an introvert, but pharmacy brought out my extroverted side. I really enjoyed talking to people and helping them."
After graduating in 1972, Moritz built a fulfilling 45-year career. During that time, he worked as a pharmacist at an independent pharmacy chain and later as a pharmacy manager and district manager for large chain stores. He retired in 2017. Now, he's giving back to the college and profession that shaped his life by establishing the Moritz Family Legacy Matching Scholars Fund to support UIC pharmacy students.
“Pharmacy has changed a lot in the five decades since I started,” Moritz reflects. “I want to give students the opportunity to explore what today’s pharmacy degree has to offer.” He has pledged $50,000 to create the scholarship. Through UIC’s Legacy Scholarship Program, his gift will receive a 50% match, bringing the total endowment to $75,000.
Before making the pledge, Moritz discussed it with his wife, Ana Vega Moritz, a former Chicago Public Schools teacher. She suggested the scholarship be awarded with preference to student members of the National Hispanic Pharmacists Association. Now, the scholarship holds special meaning to both of them. “One day when we’re gone,” says Moritz, “there will be a pharmacy student asking, ‘Who’s this Moritz family, and why are they helping fund my education?’”
Dean Glen Schumock emphasizes the lasting impact of gifts like Moritz’s. “Endowed funds provide reliable financial support year after year. We can use endowed scholarships to recruit outstanding students and support them throughout their academic journey,” he says. “We’re incredibly grateful to Mike and donors like him, and we’re honored to be entrusted with this part of his legacy.”
Moritz understands the high demand for student financial aid. “When I worked for a large chain in Minnesota, I’d go to colleges to recruit graduating pharmacists. I remember asking one senior, ‘How much debt are you carrying?’ He said he was carrying a six-figure student loan. This was more than 20 years ago. It blew me away.”
Moritz likes the idea that his scholarship will help reduce how much future students need to borrow. “I can't give them better grades,” he notes, “but I can help ease their financial burden so they can focus more on their studies.”
Endowed scholarships are especially valuable because they provide a reliable annual source of student financial support. The UIC Retzky College of Pharmacy’s Legacy Scholarship Program offers generous matching opportunities to donors:
Gifts between $50,000 and $99,999 receive a 50% match
Gifts between $100,000 and $1 million receive a 100% match
Donors may pledge gifts over time, with matching funds applied upon full pledge fulfillment
An endowed fund’s principal is invested, and the fund’s earnings are used to support students. Funds can be named by their donors and are established in perpetuity.
QUESTIONS?
Please contact senior director of development Derrick Collins at dmc22@uic.edu or call 312.996.3376.

BY JESSICA CANLAS
As senior vice president of pharmacy services at OSF HealthCare, Sandra Salverson, PharmD ’96, boasts a career spanning more than three decades. Her reputation as a dedicated and knowledgeable leader precedes her, but the start of her journey was uncertain until a pivotal experience changed the course of her life.
Born and raised on the South Side of Chicago, Salverson entered Augustana College in Rock Island, Illinois, as a premed major. Within the first two months of her freshman year, however, Salverson became ill, received treatment at the campus clinic, then visited her local pharmacy for help in sorting out her prescriptions and the OTC remedies she’d begun taking. Unfortunately, Salverson didn’t get the answers she was looking for.
She ended up having an anaphylactoid reaction to her medications and was hospitalized. Fortunately, she recovered, but the experience impacted her deeply, sending her on a quest that would become the drive behind her professional endeavors.
“The patient counseling [I received] . . . changed the course of my path. I decided to finish college in three years and go to pharmacy school.”
Surely, there was a way for pharmacists to prevent what had happened to her, she thought.
Salverson went to UIC with an open mind, taking a variety of electives to expose herself to different elements of the profession. She admits that she “didn’t say no to a lot of things.”
By the time she earned her PharmD in 1996, she already had some retail experience under her belt, but was looking for more. She was intrigued by recent legislation that mandated improved patient counseling for Medicaid recipients.
“It disturbed me that we had to tell [pharmacists] to counsel patients,” she recalls. She felt challenged to answer what seemed to her to be key questions for the profession: “How do you solve drug-related problems? What is ‘quality care’? [Those questions have] always been a theme in what I’ve done.”
To that end, Salverson decided to pursue a pharmacy practice residency at the University of Utah Hospitals and Clinics. She was looking to accelerate the conversation around improving patient interactions and have a look at how things could be done differently.
After residency, Salverson and her husband, an agricultural engineer, decided to return to the Midwest. She took on a position at Wesley Medical Center in Wichita, Kansas. At the time, the development of standardized patient safety measures was in its infancy, and Salverson focused on pursuing best practices in counseling patients, as well as how pharmacists should assert themselves in interdisciplinary environments.
Within a year, her husband got a job opportunity in Omaha, Nebraska, and Salverson was off to the University of Nebraska Medical Center, where she became “a jack of all trades.”
Her diverse experience in areas like formulary management and drug policy gave her flexibility, and she took on a position in drug information. While there, Salverson also assisted in the University of Nebraska College of Pharmacy’s IPPE program.
“That was a pivotal experience for me,” she says. “It showed me what it would mean to lead, and how someone could impact a larger population.”
Four years later, Salverson and her growing family moved to Peoria, Illinois, where she began working at OSF
St. Francis Medical Center in drug information and infectious disease.
“Then a couple of things happened,” she recalls. “There were initial discussions around antimicrobial stewardship . . . and ‘To Err is Human’ was published.”
“To Err Is Human: Building a Safer Health System” was a landmark report published in 1999 by the U.S. Institute of Medicine that shed much-needed light on medical error in the United States.
Seeing an opportunity to combine her drug information skills with her infectious disease expertise while pursuing her goal of redefining patient care, Salverson took on a role as medication safety officer. During that time, she learned make recommendations for a global population, as well as how to integrate technology in that process.
Her team established an anticoagulation service with the goal of reducing bleeding events by 80 percent.
“That made me feel good. Pharmacists have a purpose—we have the drug knowledge and expertise to prevent those things from happening [to patients].”
Two years later, her husband was transferred to upstate New York, where she eventually became manager of clinical pharmacy services for St. Peter’s Health Partners in Albany, which had recently been born out of a four-hospital merger. Here, Salverson learned how to balance safety, efficacy, and cost while navigating the intricacies of a health system merger. She also oversaw their residency program, giving her the opportunity to mentor the next generation of pharmacists.
Four years later, Salverson’s family returned to Peoria, and she became vice president of pharmacy operations for OSF HealthCare. Within eight years, she
assumed her current title of senior vice president of pharmacy services, and now oversees all pharmacy services for OSF, which includes 17 hospitals, 6 community pharmacies, 1 specialty pharmacy, 1 home infusion pharmacy, and a digital pharmacy service throughout the state of Illinois.
Salverson has worked to restructure and optimize OSF’s business model with the goal of offering the highest quality care to all the communities they serve. All 17 hospitals, including rural locations, now offer 24/7 care. The health system also offers an antimicrobial stewardship program, anticoagulation dosing services, and discharge medication reconciliation review at all locations
“Now we are on the continued journey of defining what quality care really means and how we should talk to patients,” says Salverson. “When you talk to patients, it makes a difference.”
Over the course of 30 years, Salverson has built her own path on a foundation of curiosity, resilience, and care. Her contributions to the field, from patient care to mentoring the next generation of pharmacists, reflect a passion and purpose that have earned her numerous accolades, including being the two-time recipient of ICHP’s Best Practice Award.
Salverson has her sights set next on garnering recognition for OSF as a whole by applying to be an ASHP Certified Center of Excellence™ in Medication-Use Safety and Pharmacy Practice.
“We did this for two reasons,” she explains. “To elevate system-based healthcare and to provide recognition for the value of high-quality services and what that can do for our patient population.
“That is a delight. Now we are leading others in implementing quality care.”
WE ARE ON THE CONTINUED JOURNEY OF DEFINING WHAT QUALITY CARE REALLY MEANS AND HOW WE SHOULD TALK TO PATIENTS.
ARTI ARAVINDAN , PharmD ’21, started a new position as senior medical writing associate at Kite Pharma.
TARA BERKSON , PharmD ’13, started a new position as director, inpatient pharmacy services, at Kaiser Permanente Northwest.
JUSTYNA BIELAK , PharmD ’23, started a new position as internal medicine clinical pharmacy practitioner at the U.S. Department of Veterans Affairs.
STEPHEN FADOWOLE , PharmD ’18, started a new position as senior manager, Patient & Community Engagement, Digital Optimization, RWE Clinical Trials, at Walgreens Clinical Trials.
NIJU GABRIEL , PharmD ’12, started a new position as a clinical pharmacist at Optum.
KARIE GELYANA , PharmD ’15, was promoted to assistant director, Healthcare Systems Marketing, at Astellas Pharma.
KENT HANSON , PharmD ’20, started a new position as senior manager, HEOR Immunology, at AbbVie.
MARILYN HILL , PharmD ’18, accepted the Vizient Pharmacy Vision Award for Excellence in Public Policy.
KELSEY JOHNSON , PharmD ’20, started a new position as clinical fertility pharmacist at CVS Specialty.
JOSEPH KALVAITIS , BS Pharm ’85, has retired as a staff pharmacist at Shirley Ryan AbilityLab (formerly the Rehabilitation Institute of Chicago) and Mount Sinai Hospital Medical Center. He looks forward to a peaceful retirement alternating between Chicago, Arizona, and Europe.
EDWARD LEE , PharmD ’09, started a new role as head of Intercontinental Access, Sustainability, and External Engagement at UCB.
KEVIN LEE , PharmD ’15, started a new position as clinical pharmacist at CVS Specialty.
NICHOLAS LUI , PharmD ’16, started a new position as director, HEOR Value Demonstration, Oncology, at Boehringer Ingelheim.
DAVID MONZON , PharmD ’23, started a new position as a pharmacist at Chewy.
CHRISTIAN SAN ANDRES , PharmD ’23, started a new position as manager, Material Review Compliance, at AbbVie.
VAISHALI SINHA , PharmD ’10, started a new position as associate vice president at Syngene International Limited.
DIVYA VASUDEVAN , PharmD ’1 5, started a new position as director, Cell Therapy (Early Assets & CD19 NEX-T), at Bristol Myers Squibb.
MEGHA VERMA , PharmD started a new position as m science liaison at Sun Pharma
ELYSE VESELY, PharmD ’18, started a new position as an oncology pharmacist at Beebe’s Tunnell Cancer Center.
SCOTT WIRTH , PharmD ’07, was promoted to senior director, Medical Affairs, at Arvinas.
TSING-YI KOH , PharmD ’07, started a new position as operations lead at Tengah General and Community Hospital in Tangah, Singapore.

THOMAS BALICH , Class of 1973, passed on September 19, 2024. Thomas was 74 years of age and a resident of Bridgeport, Illinois.
NORBERT J. DYBAS , Class of 1958, passed on September 27, 2024. Norbert was 88 years of age and a resident of Chicago, Illinois.
JOSEPH A. KRITZMAN , Class of 1959, passed on September 20, 2024. Joseph was 92 years of age and a resident of Morton Grove, Illinois.
NANCY A. MURPHY, Class of 1957, passed on October 8, 2024. Nancy was 89 years of age and a resident of Chicago, Illinois.

EUGENE R. NEWBERRY, Class of 1954, passed on August 19, 2024. Eugene was 93 years of age and a resident of Oak Park, Illinois.

HONORS CONVOCATION
Saturday, April 5
UIC COMMENCEMENT AND GOLDEN GRADS CELEBRATION (CLASS OF 1975)
Thursday, May 8 ALUMNI REUNION
Saturday, October 4